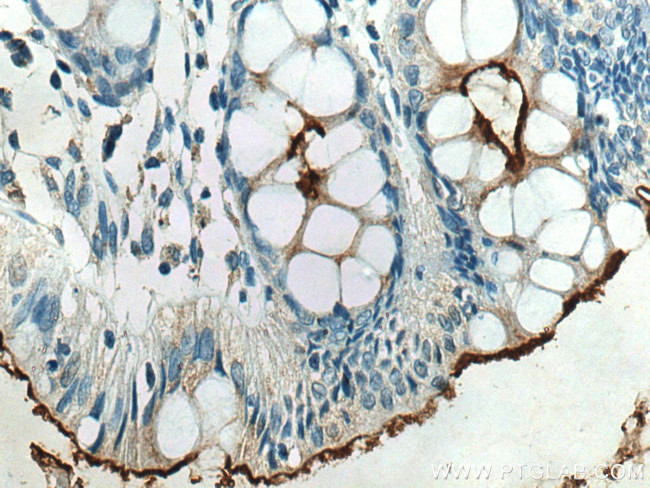
CEACAM7 Antibody in Immunohistochemistry (Paraffin) (IHC (P))

Search
Proteintech
CEACAM7 Polyclonal Antibody
{{$productOrderCtrl.translations['antibody.pdp.commerceCard.promotion.promotions']}}
{{$productOrderCtrl.translations['antibody.pdp.commerceCard.promotion.viewpromo']}}
{{$productOrderCtrl.translations['antibody.pdp.commerceCard.promotion.promocode']}}: {{promo.promoCode}} {{promo.promoTitle}} {{promo.promoDescription}}. {{$productOrderCtrl.translations['antibody.pdp.commerceCard.promotion.learnmore']}}
产品信息
24626-1-AP
种属反应
宿主/亚型
分类
类型
抗原
偶联物
形式
浓度
规格
纯化类型
保存液
内含物
保存条件
运输条件
产品详细信息
Immunogen sequence: VTHNDAGIYT LHVIKENLVN EEVTRQFYVF SEPPKPSITS NNFNPVENKD IVVLTCQPET QNTTYLWWVN NQSLLVSPRL LLSTDNRTLV LLSATKNDIG P
靶标信息
CEACAM7 is a CEA-related cell adhesion molecule 7 that belongs to the carcinoembryonic antigen (CEA) family. CEACAM7 encodes a glycosyl phosphatidyl inositol (GPI)-linked glycoprotein which is only found on the apical surface of highly differentiated epithelial cells adult colon and on a small epithelial cell population in pancreatic ducts. CEACAM7 expression is completely lost upon malignant transformation already in hyperplastic polyps and early adenomas as well as in adenocarcinomas of the colon. Like all members of the CEACAM family, it consists of a single N domain, with structural homology to the immunoglobulin variable domains, followed by one immunoglobulin constant-like A domain.
仅用于科研。不用于诊断过程。未经明确授权不得转售。
篇参考文献 (0)
生物信息学
蛋白别名: BGP; BGP7; Carcinoembryonic antigen CGM2; carcinoembryonic antigen gene family member 2; carcinoembryonic antigen related cell adhesion molecule 7; Carcinoembryonic antigen-related cell adhesion molecule 7; CEA; CEA cell adhesion molecule 7; CEA gene family member 2a; CEA gene family member 2b; Cell adhesion molecule CEACAM7; unnamed protein product
基因别名: CEACAM7; CGM2
UniProt ID: (Human) Q14002
Entrez Gene ID: (Human) 1087